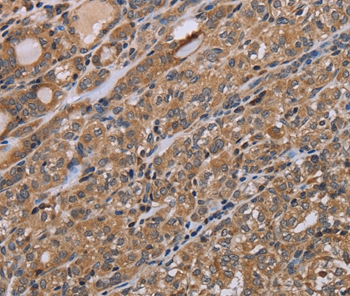
产品细节图片1

相关产品推荐更多 >
万千商家帮你免费找货
0 人在求购买到急需产品
- 详细信息
- 文献和实验
- 技术资料
- 免疫原:
Synthetic peptide corresponding to a region derived from internal residues of human N(alpha)-acetyltransferase 25, NatB auxiliary subunit
- 形态:
liquid
- 保存条件:
Store at -20˚C
- 克隆性:
Polyclonal
- 适应物种:
Human
- 保质期:
12 months
- 抗原来源:
Rabbit
- 供应商:
南京赛戈巍生物科技有限公司
- 宿主:
Rabbit
- 应用范围:
IHC
- 靶点:
Uniprot:Q14CX7
- 抗体英文名:
NAA25 Antibody
- 规格:
50ul/100ul
配方:Rabbit IgG in pH7.3 PBS, 0.05% NaN3, 50% Glycerol.
应用详情:Immunohistochemistry: 1:50-1:200
图片:
Immunohistochemical analysis of paraffin-embedded Human thyroid cancer tissue using #37753 at dilution 1/40.
,

Immunohistochemical analysis of paraffin-embedded Human brain tissue using #37753 at dilution 1/40.
风险提示:丁香通仅作为第三方平台,为商家信息发布提供平台空间。用户咨询产品时请注意保护个人信息及财产安全,合理判断,谨慎选购商品,商家和用户对交易行为负责。对于医疗器械类产品,请先查证核实企业经营资质和医疗器械产品注册证情况。
文献和实验人25羟维生素D3(25(OH)D3)酶联免疫分析(ELISA)
人 25羟维生素D3(25(OH)D3) 酶联免疫 分析( ELISA ) 试剂 盒使用说明书 本试剂仅供研究使用 目的:本试剂盒用于测定人血清,血浆及相关液体样本中25羟维生素D3(25(OH)D3)含量。 实验原理 : 本试剂盒应用双抗体夹心法测定 标本 中 人25 羟维生素 D3 ( 25(OH)D3 ) 水平。用纯化的 人25 羟维生素 D3 ( 25(OH)D3 ) 抗体包被微孔板,制成固相抗体,往包
人25羟基维生素D(25-OH-D)酶联免疫分析(ELISA)
人 25 羟基维生素 D(25 - OH - D ) 酶联免疫 分析( ELISA ) 试剂 盒使用说明书 本试剂仅供研究使用 目的:本试剂盒用于测定人血清,血浆及相关液体样本中 25羟基维生素D(25 - OH - D) 的 含量。 实验原理 : 本试剂盒应用双抗体夹心法测定 标本 中 人 25 羟基维生素 D(25 - OH - D ) 水平。用纯化的 抗 D(25 - OH - D ) 抗体包被微孔板,制成固相
萘乙酸(naphthalene acetic acid,NAA)
一种人工合成的具有与生长素类似生理效应的有机物。有效成分为α -NAA,分子式 C12 H10 O2 ,白色结晶,不溶于水,溶于酒精等有机溶剂,其钠盐溶于水,效应与 NAA相同,但应用浓度较高。生产容易,活性强,为农业及园艺上使用最广泛的人工合成生长素之一。它可以促进发芽、单性结实及花芽形成(波罗),抑制器官脱落以及刺激插枝生根等。由于生根量少且较粗,故宜与吲哚丁酸(刺激插枝生根数目多且较细)共用。
技术资料暂无技术资料 索取技术资料





![EGFL6 Antibody[35722]](https://img1.dxycdn.com/p/s14/2025/0922/359/6146153295428599691.jpg!wh200)
![SCIN Polyclonal Antibody[30184]](https://img1.dxycdn.com/p/s14/2025/0923/305/2150219664296040791.jpg!wh200)
![FOXG1 Antibody[40353]](https://img1.dxycdn.com/p/s14/2025/0922/568/0046652811090600791.jpg!wh200)

